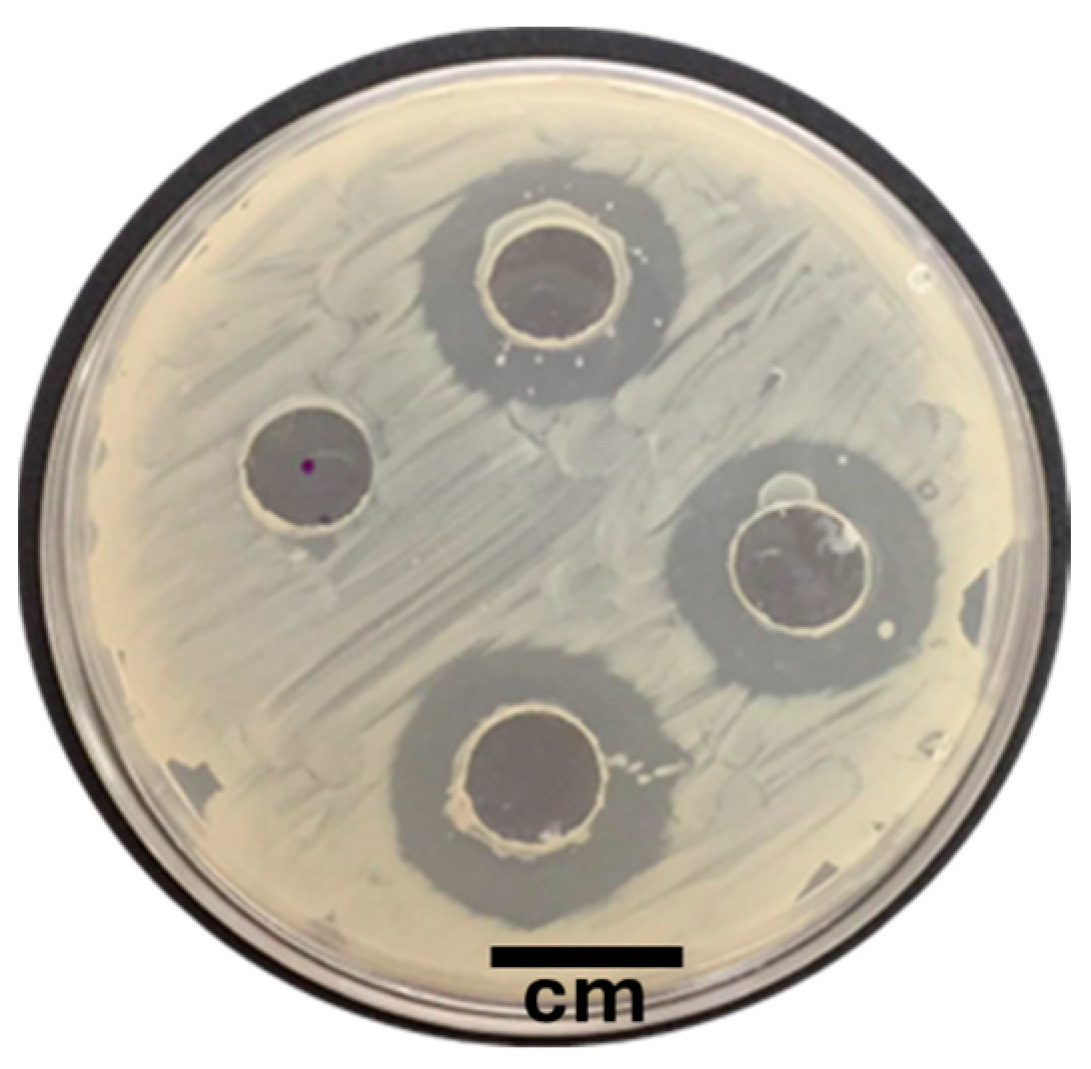
Microorganisms 12 01623 g001

Genomic Characterization of Bacillus pumilus Sonora, a Strain with Inhibitory Activity against Vibrio parahaemolyticus-AHPND and Probiotic Candidate for Shrimp Aquaculture
Abstract
1. Introduction
Ethics Statement
2. Materials and Methods
2.1. Origin of Bacterial Strains
2.2. Assessment of Antibacterial Activity Based on the Well Diffusion Test
2.3. Assessment of Antibacterial Activity Based on the Double Layer Assay
2.4. Hemolytic Activity
2.5. Extracellular Enzymatic Activity
2.6. Biofilm Rupture Assay
2.7. Test for In Vivo Antagonist Assessment in Bioassays
2.7.1. Diet Preparation
2.7.2. Challenge Test
2.7.3. Diagnosis of VpAHPND by qPCR
2.8. Whole Genome Sequencing of the Sonora Isolate
2.8.1. Extraction of Genomic DNA from a Sonora Isolate
2.8.2. Sample Tagging
2.8.3. De Novo Assembly, Genome Annotation, Phylogenetic Analysis, and Identification of Genes Involved in the Biosynthesis of AMP-Related Genes
2.9. Statistical Analysis
3. Results
3.1. In Vitro Evaluation of the Antagonistic Activity of the Isolates against VpAHPND D11F
3.2. Hemolytic Activity and Enzymatic Activity
3.3. Inhibition of Preformed Biofilms
3.4. Challenge Trial of the Sonora Strain against VpAHPND and qPCR Results
3.5. De Novo Assembly, Annotation, and Phylogenetic Analysis of the Sonora Isolate
Genes Related to the Synthesis of AMP-Related Genes
4. Discussion
Author Contributions
Funding
Data Availability Statement
Acknowledgments
Conflicts of Interest
References
- Stieglitz, J.D.; Touchton, M.; Benetti, D.D.; Rothen, D.; Clark-Hughes, A.; Haus, B.K.; Zangroniz, A.; Suman, D.O. Chapter 5: Global Marine Aquaculture Development. In Ocean and Society an Introduction to Marine Studies; Spalding, A., Suman, D., Eds.; Routledge: London, UK, 2023; pp. 59–78. [Google Scholar] [CrossRef]
- Food and Agriculture Organization of the United Nations. The State of World Fisheries and Aquaculture Blue Transformation in Action; FAO: Rome, Italy, 2024; 264p. [Google Scholar] [CrossRef]
- Soo, T.C.C.; Bhassu, S. Signature selection forces and evolutionary divergence of immune-survival genes compared between two important shrimp species. PLoS ONE 2023, 18, e0280250. [Google Scholar] [CrossRef] [PubMed]
- [CONAPESCA] Comisión Nacional de Acuacultura y Pesca. Anuario Estadístico de Acuacultura y Pesca. CONAPESCA, México. 2021. Available online: https://nube.conapesca.gob.mx/sites/cona/dgppe/2021/ANUARIO_ESTADISTICO_DE_ACUACULTURA_Y_PESCA_2021.pdf (accessed on 14 June 2024).
- Asche, F.; Anderson, J.L.; Botta, R.; Kumar, G.; Abrahamsen, E.B.; Nguyen, L.T.; Valderrama, D. The economics of shrimp disease. J. Invertebr. Pathol. 2021, 186, 107397. [Google Scholar] [CrossRef] [PubMed]
- Soto-Rodriguez, S.A.; Lozano-Olvera, R.; Ramos-Clamont, M.G.; Zenteno, E.; Sanchez-Salgado, J.L.; Vibanco-Perez, N.; Aguilar-Rendon, K.G. New insights into mechanism of action of PirAB from Vibrio parahemolyticus. Toxins 2022, 14, 243. [Google Scholar] [CrossRef]
- Joshi, J.; Srisala, J.; Truong, V.H.; Chend, T.I.; Nuangsaenge, B.; Suthienkul, O.; Lo, C.F.; Flegel, T.W.; Sritunyalucksana, K.; Thitamadee, S. Variation in Vibrio parahaemolyticus isolates from a single Thai shrimp farm experiencing an outbreak of acute hepatopancreatic necrosis disease (AHPND). Aquaculture 2014, 428–429, 297–302. [Google Scholar] [CrossRef]
- Gonzalez-Gomez, J.P.; Soto-Rodriguez, S.; Lopez-Cuevas, O.; Castro-Del Campo, N.; Chaidez, C.; Gomez-Gil, B. Phylogenomic analysis supports two possible origins for Latin American strains of Vibrio parahemolyticus associated with acute hepatopancreatic necrosis disease (AHPND). Curr. Microbiol. 2020, 7, 3851–3860. [Google Scholar] [CrossRef] [PubMed]
- Dhar, A.K.; Piamsomboon, P.; Aranguren-Caro, L.F.; Kanrar, S.; Adami, R.; Juan, Y.S. First report of acute hepatopancreatic necrosis disease (AHPND) occurring in the USA. Dis. Aquat. Org. 2019, 132, 241–247. [Google Scholar] [CrossRef] [PubMed]
- Han, J.E.; Choi, S.K.; Han, S.-H.; Lee, S.C. Genomic and histopathological characteristics of Vibrio parahaemolyticus isolated from an acute hepatopancreatic necrosis disease outbreak in Pacific white shrimp (Penaeus vannamei) cultured in Korea. Aquaculture 2020, 524, 735284. [Google Scholar] [CrossRef]
- Tang, K.F.J.; Bondad-Reantaso, M.G.; Arthur, J.R.; MacKinnon, B.; Hao, B.; Alday-Sanz, V.; Liang, Y.; Dong, X. Shrimp Acute Hepatopancreatic Necrosis Disease Strategy Manual; FAO Fisheries and Aquaculture Circular 1190; FAO: Rome, Italy, 2020; 80p. [Google Scholar] [CrossRef]
- Kumar, V.; Roy, S.; Kumar, M.D.; Kumar, S.U. Application of probiotics in shrimp aquaculture: Importance, mechanism of action, and methods of administration. Rev. Fish. Sci. Aquac. 2016, 24, 342–368. [Google Scholar] [CrossRef]
- Food and Agricultural Organization of the United Nations. Report on Joint FAO/WHO Expert Consultation on Evaluation of Health and Nutritional Properties of Probiotics in Food Including Powder Milk with Live Lactic Acid Bacteria; FAO: Cordoba, Spain, 2001; 30p. [Google Scholar]
- Verschuere, L.; Rombaut, G.; Sorgeloos, P.; Verstrae, W. Probiotic bacteria as biological control agents in aquaculture. Microbiol. Mol. Biol. Rev. 2000, 64, 655–671. [Google Scholar] [CrossRef] [PubMed]
- Decamp, O.; Moriarty, D.J.W.; Lavens, P. Probiotics for shrimp larviculture: Review of field data from Asia and Latin America. Aquac. Res. 2008, 39, 334–338. [Google Scholar] [CrossRef]
- Rengipipat, S.; Rukprantanporn, S.; Piyatiratitivorakul, S.; Menasaveta, P. Immunity enhancement in black tiger shrimp (Penaeus monodon) by a probiont bacterium (Bacillus S11). Aquaculture 2000, 191, 271–288. [Google Scholar] [CrossRef]
- Vaseeharan, B.; Ramasamy, P. Control of pathogenic Vibrio spp. by Bacillus subtilis BT23, a possible probiotic treatment for black tiger shrimp Panaeus monodon. Appl. Microbiol. Int. 2003, 36, 83–87. [Google Scholar] [CrossRef] [PubMed]
- Chen, Y.-A.; Chiu, W.-C.; Wang, T.-Y.; Wong, H.; Tang, C.-T. Isolation and characterization of an antimicrobial Bacillus subtilis strain O-741 against Vibrio parahaemolyticus. PLoS ONE 2024, 19, e0299015. [Google Scholar] [CrossRef] [PubMed]
- Proespraiwong, P.; Mavichak, R.; Imaizumi, K.; Hirono, I.; Unajak, S. Evaluation of Bacillus spp. as potent probiotics with reduction in AHPND-related mortality and facilitating growth performance of Pacific white shrimp (Litopenaeus vannamei) farms. Microorganisms 2023, 11, 2176. [Google Scholar] [CrossRef] [PubMed]
- Chauyod, K.; Rattanavarin, K.; Sarapukdee, P.; Porntheeraphat, S.; Sritunyalucksana, K.; Khemthongcharoen, N. Bacillus velezensis suppression on the growth of Vibrio parahaemolyticus causing acute hepatopancreatic necrosis disease in marine shrimp. J. Appl. Aquac. 2023, 35, 1202–1216. [Google Scholar] [CrossRef]
- Galaviz-Silva, L.; Robles-Valdez, A.; Sánchez-Díaz, R.; Ibarra-Gamez, J.C.; Gómez-Gil, B.; Molina-Garza, Z.J. Cepas de Vibrio parahaemolyticus que causan necrosis hepatopancreática aguda en camarón cultivado de Sonora, México y su resistencia a antibióticos. Hidrobiológica 2021, 31, 111–123. [Google Scholar] [CrossRef]
- Trinh Ngoc, A.; Nguyen Thanh, T.; Huynh Kim, H.; Pham Kim, L.; Huynh Truong, G.; Truong Quoc, P. Selection of lactic acid bacteria (LAB) antagonizing Vibrio parahaemolyticus: The pathogen of acute hepatopancreatic necrosis disease (AHPND) in whiteleg shrimp (Penaeus vannamei). Biology 2019, 8, 91. [Google Scholar] [CrossRef] [PubMed]
- Santos-Beneit, F.; Ceniceros, A.; Nikolaou, A.; Salas, J.A.; Gutierrez-Merino, J. Identification of antimicrobial compounds in two Streptomyces sp. strains isolated from beehives. Front. Microbiol. 2022, 13, 742168. [Google Scholar] [CrossRef] [PubMed]
- Galaviz-Silva, L.; Cázares-Jaramillo, G.E.; Ibarra-Gámez, J.C.; Molina-Garza, V.M.; Sánchez-Díaz, R.; Molina-Garza, Z.J. Assessment of probiotic bacteria from marine coasts against Vibrio parahaemolyticus (AHPND strains) in Litopenaeus vannamei. Aquac. Res. 2021, 52, 6396–6409. [Google Scholar] [CrossRef]
- Schneider, C.A.; Rasband, W.S.; Eliceiri, K.W. NIH Image to ImageJ: 25 years of image analysis. Nat. Methods 2012, 9, 671–675. [Google Scholar] [CrossRef] [PubMed]
- Luo, J.; Wang, Y.; Tang, S.; Liang, J.; Lin, W.; Luo, L. Isolation and identification of algicidal compound from Streptomyces and algicidal mechanism to Microcystis aeruginosa. PLoS ONE 2013, 8, e76444. [Google Scholar] [CrossRef] [PubMed]
- Avendaño-Herrera, R.; Lody, M.; Riquelme, C.E. Production of inhibitory substances among bacterial biofilms on marine substrates. Rev. Biol. Mar. Oceanogr. 2005, 40, 117–125. [Google Scholar] [CrossRef]
- López-León, P.; Luna-González, A.; Escamilla-Montes, R.; Flores-Miranda, M.C.; Fierro-Coronado, J.A.; Álvarez-Ruiz, P.; Diarte-Plata, G. Isolation and characterization of infectious Vibrio parahaemolyticus, the causative agent of AHPND, from the whiteleg shrimp (Litopenaeus vannamei). Lat. Am. J. Aquat. Res. 2016, 44, 470–479. [Google Scholar] [CrossRef]
- Sánchez, T.; León, J.; Woolcott, J.; Arauco, K. Extracellular proteases produced by marine bacteria isolated from sea water contaminated with fishing effluents. Rev. Peru. Biol. 2004, 11, 179–186. [Google Scholar] [CrossRef]
- Famuyide, I.; Aro, A.; Fasina, F.; Eloff, J.; McGaw, L. Antibacterial and antibiofilm activity of acetone leaf extracts of nine under-investigated south African Eugenia and Syzygium (Myrtaceae) species and their selectivity indices. BMC Complement. Altern. Med. 2019, 19, 141. [Google Scholar] [CrossRef] [PubMed]
- Manilal, A.; Selvin, J.; Sugathan, S.; Panikkar, M.V.N. Evaluation of therapeutic efficacy of Indian green alga, Acrosiphonia orientalis (j. agardh) in the treatment of vibriosis in Penaeus monodon. Thalassas 2011, 28, 33–46. [Google Scholar]
- Sugathan, S.; Manilal, A.; Selvin, J. Development of a Probiotic for the Management of Shrimp Vibriosis; Scholars’ Press: London, UK, 2014; pp. 96–98. Available online: https://www.perlego.com/book/3221029/development-of-novel-probiotic-for-the-management-of-shrimp-vibriosis-pdf (accessed on 1 May 2024).
- Sánchez-Diaz, R.; Molina-Garza, Z.; Cruz-Suarez, L.E.; Selvin, J.; Kiran, G.S.; Gómez-Gil, B.; Galaviz-Silva, L.; Ibarra-Gámez, J.C. Draft genome sequences of Bacillus pumilus 36R ATNSAL and B. safensis 13L LOBSAL, two potential candidate probiotic strains for shrimp aquaculture. J. Glob. Antimicrob. Resist. 2022, 31, 304–308. [Google Scholar] [CrossRef]
- Soto-Rodriguez, S.A.; Gomez-Gil, B.; Lozano-Olvera, R.; Betancourt-Lozano, M.; Morales-Covarrubias, M.S. Field and experimental evidence of Vibrio parahaemolyticus as the causative agent of acute hepatopancreatic necrosis disease of cultured shrimp (Litopenaeus vannamei) in Northwestern Mexico. Appl. Environ. Microbiol. 2015, 81, 1689–1699. [Google Scholar] [CrossRef] [PubMed]
- Chen, W.; Hann Ng, T.; Wu, J.; Chen, J.; Wang, H. Microbiome dynamics in a shrimp grow-out pond with possible outbreak of acute hepatopancreatic necrosis disease. Sci. Rep. 2017, 7, 9395. [Google Scholar] [CrossRef] [PubMed]
- Bankevich, A.; Nurk, S.; Antipov, D.; Gurevich, A.A.; Dvorkin, M.; Kulikov, A.S.; Lesin, V.M.; Nikolenko, S.I.; Pham, S.; Prjibelski, A.D.; et al. SPAdes: A new genome assembly algorithm and its applications to single-cell sequencing. J. Comput. Biol. 2012, 19, 455–477. [Google Scholar] [CrossRef]
- Medema, M.H.; Blin, K.; Cimermancic, P.; de Jager, V.; Zakrzewski, P.; Fischbach, M.A.; Weber, T.; Takano, E.; Breitling, R. AntiSMASH: Rapid identification, annotation and analysis of secondary metabolite biosynthesis gene clusters in bacterial and fungal genome sequences. Nucleic Acids Res. 2011, 39, W339–W346. [Google Scholar] [CrossRef] [PubMed]
- Leyton, Y.; Borquez, J.; Darias, J.; Cueto, M.; Días, A.; Riquelme, C. Diketoppiperazines produced by a Bacillus species inhibits Vibrio parahaemolyticus. J. Aquacult Res. Dev. 2012, 3, 144. [Google Scholar]
- Velmurugan, S.; Raman, K.; Thanga, V.; Viji, M.B.S.; Donio, J.; Adlin, J.; Babu, M.M.; Citarasu, T. Screening and characterization of antimicrobial secondary metabolites from Halomonas salifodinae MPM-TC and its in vivo antiviral influence on Indian white shrimp Fenneropenaeus indicus against WSSV challenge. J. King Saud Univ. Sci. 2013, 25, 181–190. [Google Scholar] [CrossRef]
- Zheng, B.; Bossier, P. Toxicity assessment and anti-Vibrio activity of essential oils: Potential for application in shrimp aquaculture. Rev. Aquac. 2023, 15, 1554–1573. [Google Scholar] [CrossRef]
- Kumar, V.; Roy, S.; Behera, B.; Bossier, P.; Das, B. Acute hepatopancreatic necrosis disease (AHPND): Virulence, pathogenesis and mitigation strategies in shrimp aquaculture. Toxins 2021, 13, 524. [Google Scholar] [CrossRef]
- Tinwongger, S.; Thawonsuwan, J.; Kondo, H.; Hirono, I. Identification of an anti-lipopolysaccharide factor AV-R isoform (LvALF AV-R) related to Vp_PirAB-like toxin resistance in Litopenaeus vannamei. Fish Shellfish Immunol. 2019, 84, 178–188. [Google Scholar] [CrossRef] [PubMed]
- Kumar, S.; Verma, A.K.; Singh, S.P.; Awasthi, A. Immunostimulants for shrimp aquaculture: Paving pathway towards shrimp sustainability. Environ. Sci. Pollut. Res. Int. 2023, 30, 25325–25343. [Google Scholar] [CrossRef] [PubMed]
- Sivakumar, N.; Sundararaman, M.; Selvakumar, G. Probiotic effect of Lactobacillus acidophilus against vibriosis in juvenile shrimp (Penaeus monodon). Afr. J. Biotecnol. 2012, 11, 15811–15818. [Google Scholar] [CrossRef]
- Burks, D.J.; Norris, S.; Kauffman, K.M.; Joy, A.; Arevalo, P.; Azad, R.K.; Wildschutte, H. Environmental vibrios represent a source of antagonistic compounds that inhibit pathogenic Vibrio cholerae and Vibrio parahaemolyticus strains. MicrobiologyOpen 2017, 6, e504. [Google Scholar] [CrossRef] [PubMed]
- Kewcharoen, W.; Srisapoome, P. Probiotic effects of Bacillus spp. from Pacific white shrimp (Litopenaeus vannamei) on water quality and shrimp growth, immune responses, and resistance to Vibrio parahaemolyticus (AHPND strains). Fish Shellfish Immunol. 2019, 94, 175–189. [Google Scholar] [CrossRef] [PubMed]
- Dawood, M.A.; Koshio, S.; Abdel-Daim, M.M.; Van Doan, H. Probiotic application for sustainable aquaculture. Rev. Aquac. 2019, 11, 907–924. [Google Scholar] [CrossRef]
- Wei, C.; Luo, K.; Wang, M.; Li, Y.; Pan, M.; Xie, Y.; Qin, G.; Liu, Y.; Li, L.; Liu, Q.; et al. Evaluation of potential probiotic properties of a strain of Lactobacillus plantarum for shrimp farming: From beneficial functions to safety assessment. Front. Microbiol. 2022, 13, 854131. [Google Scholar] [CrossRef] [PubMed]
- Nithya, C.; Devi, M.G.; Pandian, S.K. A novel compound from the marine bacterium Bacillus pumilus S6-15 inhibits biofilm formation in Gram-positive and Gram-negative species. Biofouling 2011, 27, 519–528. [Google Scholar] [CrossRef] [PubMed]
- Lee, C.; Han, J.E.; Kim, J.E.; Kim, S.H.; Kim, J.W.; Eun, J.S.; Lee, K.J. Effect of dietary supplementation of Bacillus spp. on growth performance, and resistance of Pacific white shrimp (Litopenaeus vannamei) to acute hepatopancreatic necrosis disease. Isr. J. Aquac. 2019, 71, 10. [Google Scholar] [CrossRef]
- Lim, S.Y.; Loo, K.W.; Wong, W.L. Synergistic antimicrobial effect of a seaweed-probiotic blend against acute hepatopancreatic necrosis disease (AHPND)-causing Vibrio parahaemolyticus. Probiotics Antimicrob. Proteins 2019, 12, 906–917. [Google Scholar] [CrossRef] [PubMed]
- Ninawe, A.S.; Selvin, J. Probiotics in shrimp aquaculture: Avenues and challenges. Crit. Rev. Microbiol. 2009, 35, 43–66. [Google Scholar] [CrossRef] [PubMed]
- Kuebutornye, F.K.A.; Abarike, E.D.; Lu, Y. A review on the application of Bacillus as probiotics in aquaculture. Fish Shellfish Immunol. 2019, 87, 820–828. [Google Scholar] [CrossRef] [PubMed]
- Pinchuk, I.V.; Bressollier, P.; Verneuil, B.; Fenet, B.; Sorokulova, I.B.; Mégraud, F.; Urdaci, C. In vitro Anti-Helicobacter pylori activity of the probiotic strain Bacillus subtilis 3 is due to secretion of antibiotics. Antimicrob. Agents Chemother. 2001, 45, 3156–3161. [Google Scholar] [CrossRef]
- Musthafa, K.S.; Saroja, V.; Pandian, S.K.; Ravi, A.V. Antipathogenic potential of marine Bacillus sp. SS4 on N-acyl-homoserine-lactone- mediated virulence factors production in Pseudomonas aureginosa (PAO1). J. Biosci. 2011, 36, 55–67. [Google Scholar] [CrossRef]
- Suva, M.; Sureja, V.; Kheni, D. Novel insight on probiotic Bacillus subtilis: Mechanism of action and clinical application. J. Curr. Res. Sci. Med. 2011, 2, 65–72. [Google Scholar] [CrossRef]
- Qureshi, K.A.; Bholay, A.D.; Elhassan, G.O.; Khan, R.A.; El-Agamy, I. Isolation, purification and characterization of bacteriocin produced by Bacillus pumilus NJ-M2; a future biopreservative. Int. J. Biol. Pharm. Allied Sci. 2016, 5, 2840–2862. [Google Scholar]
- Stepanov, V.G.; Tirumalai, M.R.; Montazari, S.; Checinska, A.; Venkateswaran, K.; Fox, G.E. Bacillus pumilus SAFR-032 Genome revisited: Sequence update and re-annotation. PLoS ONE 2016, 11, e0157331. [Google Scholar] [CrossRef] [PubMed]
- Rabbee, M.F.; Baek, K.H. Antimicrobial activities of lipopeptides and polyketides of Bacillus velezensis for agricultural applications. Molecules 2020, 25, 4973. [Google Scholar] [CrossRef] [PubMed]
- Kumar, R.A.; Prasad, R.V.; Nagarajan, S. Chapter 23: Antibiofilm activities against food pathogens. In Applications of Next Generation Biosurfactants in the Food Sector; Academic Press: New York, NY, USA, 2023; pp. 479–508. [Google Scholar]
- Sur, S.; Romo, T.D.; Grossfield, A. Selectivity and mechanism of fengycin, an antimicrobial lipopeptide from molecular dynamics. J. Phys. Chem. 2018, 122, 2219–2226. [Google Scholar] [CrossRef] [PubMed]
- Stintzi, A.; Barnes, C.; Xu, J.; Raymond, K.N. Microbial iron transport via a siderophore shuttle: A membrane ion transport paradigm. Proc. Natl. Acad Sci. USA 2000, 97, 10691–10696. [Google Scholar] [CrossRef]
- Wang, S.; Pearson, L.A.; Mazmous, R.; Liu, T.; Neilan, B. Heterologous expression and biochemical analysis reveal a schizokinen -based siderophore pathway in Leptolyngbya (Cyanobacteria). Appl. Environ. Microbiol. 2022, 88, e02373-21. [Google Scholar] [CrossRef]
- Wu, L.; Wu, H.; Chen, L.; Xie, S.; Zang, H.; Borris, R.; Gao, X. Bacilysin from Bacillus amyloliquefaciens FZB42 has specific bactericidal activity against harmful algal bloom species. Appl. Environ. Microbiol. 2014, 80, 7512–7520. [Google Scholar] [CrossRef] [PubMed]
- Wang, J.; Zhang, D.; Wang, Y.; Lui, Z.; Lui, L.; Shi, C. Probiotic effects of Bacillus velezensis GY65 stran in the mandarin fish, Siniperca chuatsi. Aquac. Rep. 2021, 21, 100902. [Google Scholar] [CrossRef]
- Wu, Q.; Throckmorton, K.; Maity, M.; Chevrette, M.G. Bacilibactins E and F from a marine sponge-associated Bacillus sp. J. Nat. Prod. 2022, 84, 136–141. [Google Scholar] [CrossRef] [PubMed]
- Chakraborty, K.; Kizhakkekalam, V.K.; Joy, M.; Chakraborty, R.D. Bacillibactin class of siderophore antibiotics from a marine symbiotic Bacillus as promising antibacterial agents. Appl. Microbiol. Biotechnol. 2022, 106, 329–340. [Google Scholar] [CrossRef] [PubMed]
- Wang, D.; Li, J.; Zhu, G.; Zhao, K.; Jiang, W.; Li, H.; Wang, W.; Kumar, V.; Dong, S.; Zhu, W.; et al. Mechanism of the potential therapeutic candidate Bacillus subtilis BSXE.-1601 against shrimp pathogenic Vibrios and multifunctional metabolites biosynthetic capability of the strain as predicted by genome analysis. Front. Microbiol. 2020, 11, 581802. [Google Scholar] [CrossRef]

| Isolates | Sample Source |
|---|---|
| 32a | Red mangrove (Rhizophora mangle) |
| 43 | Chinese clam (Iliochione subrugosa) |
| Sonora | Saline sediment |
| Y119 | Seawater |
| HA | Mangle mud |
| J1 | Seawater |
| H3M | Seawater |
| H2 | Hermit crab (Clibanarius panamensis) |
| G2.1 | Green seaweed (Enteromorpha sp.) |
| G2 | Green seaweed (Enteromorpha sp.) |
| G3.2 | Green seaweed (Rhizoclonium sp.) |
| E2.1 | Seawater |
| G10 | Saline sediment |
| 36R | Saline sediment |
| Strain | Hemolysis | Enzymatic Activity | ||
|---|---|---|---|---|
| Protease | Amylase | Cellulase | ||
| H3M | γ | − | + | − |
| H2 | γ | − | − | + |
| Sonora | γ | + | − | + |
| E2.1 | γ | + | − | + |
| HA | γ | − | − | + |
| 43 | γ | + | − | + |
| G2.1 | γ | − | − | + |
| G3.2 | α | + | − | + |
| Y119 | α | − | − | + |
| G10 | β | + | − | + |
| J1 | β | − | − | + |
| G2 | N/D | + | + | + |
| 32a | N/D | + | − | − |
| Feature | Counts |
|---|---|
| Genome length | 3,512,470 bp |
| GC content | 41.74% |
| Plasmid | 0 |
| Contig L50 | 4 |
| Contig N50 | 264,060 |
| Number of coding sequences | 3734 |
| Number of subsystems | 327 |
| tRNA | 70 |
| rRNA | 10 |
| Type | Most Similar Known Biosynthetic Gene Cluster |
|---|---|
| NRPS | Surfactin |
| Betalactone | Fengycin |
| Terpene | N/D |
| RRE-containing | Schizokinen |
| Betalactone | N/D |
| RiPP-like | N/D |
| T3PKS | N/D |
| NRP-metallopore | Bacillibactin |
| NRPS, T1KPKS | Paenilamicin |
| (2) NRPS | Lichenysin |
| Other | Bacilysin |
| Bacillus pumilus Sonora | Bacillus pumilus SAFR 032 | Bacillus pumilus 36R | |
|---|---|---|---|
| Genome length | 3,600,890 bp | 3,704,641 bp | 3,941,096 bp |
| Contigs | 37 | 1 | 283 |
| %GC content | 41.74% | 41.5% | 41.1% |
| N50 | 264,060 bp | 3.7 Mb | 49,075 bp |
| Protein-coding genes | 3734 | 3710 | 3947 |
| tRNA | 70 | 72 | 70 |
| rRNA | 10 | 21 | 14 |
Disclaimer/Publisher’s Note: The statements, opinions and data contained in all publications are solely those of the individual author(s) and contributor(s) and not of MDPI and/or the editor(s). MDPI and/or the editor(s) disclaim responsibility for any injury to people or property resulting from any ideas, methods, instructions or products referred to in the content. |
© 2024 by the authors. Licensee MDPI, Basel, Switzerland. This article is an open access article distributed under the terms and conditions of the Creative Commons Attribution (CC BY) license (https://creativecommons.org/licenses/by/4.0/).
Share and Cite
Soto-Marfileño, K.A.; Molina Garza, Z.J.; Flores, R.G.; Molina-Garza, V.M.; Ibarra-Gámez, J.C.; Gil, B.G.; Galaviz-Silva, L. Genomic Characterization of Bacillus pumilus Sonora, a Strain with Inhibitory Activity against Vibrio parahaemolyticus-AHPND and Probiotic Candidate for Shrimp Aquaculture. Microorganisms 2024, 12, 1623. https://doi.org/10.3390/microorganisms12081623
Soto-Marfileño KA, Molina Garza ZJ, Flores RG, Molina-Garza VM, Ibarra-Gámez JC, Gil BG, Galaviz-Silva L. Genomic Characterization of Bacillus pumilus Sonora, a Strain with Inhibitory Activity against Vibrio parahaemolyticus-AHPND and Probiotic Candidate for Shrimp Aquaculture. Microorganisms. 2024; 12(8):1623. https://doi.org/10.3390/microorganisms12081623
Chicago/Turabian StyleSoto-Marfileño, Karla A., Zinnia Judith Molina Garza, Ricardo Gomez Flores, Vida Mariel Molina-Garza, José C. Ibarra-Gámez, Bruno Gómez Gil, and Lucio Galaviz-Silva. 2024. "Genomic Characterization of Bacillus pumilus Sonora, a Strain with Inhibitory Activity against Vibrio parahaemolyticus-AHPND and Probiotic Candidate for Shrimp Aquaculture" Microorganisms 12, no. 8: 1623. https://doi.org/10.3390/microorganisms12081623
APA StyleSoto-Marfileño, K. A., Molina Garza, Z. J., Flores, R. G., Molina-Garza, V. M., Ibarra-Gámez, J. C., Gil, B. G., & Galaviz-Silva, L. (2024). Genomic Characterization of Bacillus pumilus Sonora, a Strain with Inhibitory Activity against Vibrio parahaemolyticus-AHPND and Probiotic Candidate for Shrimp Aquaculture. Microorganisms, 12(8), 1623. https://doi.org/10.3390/microorganisms12081623

